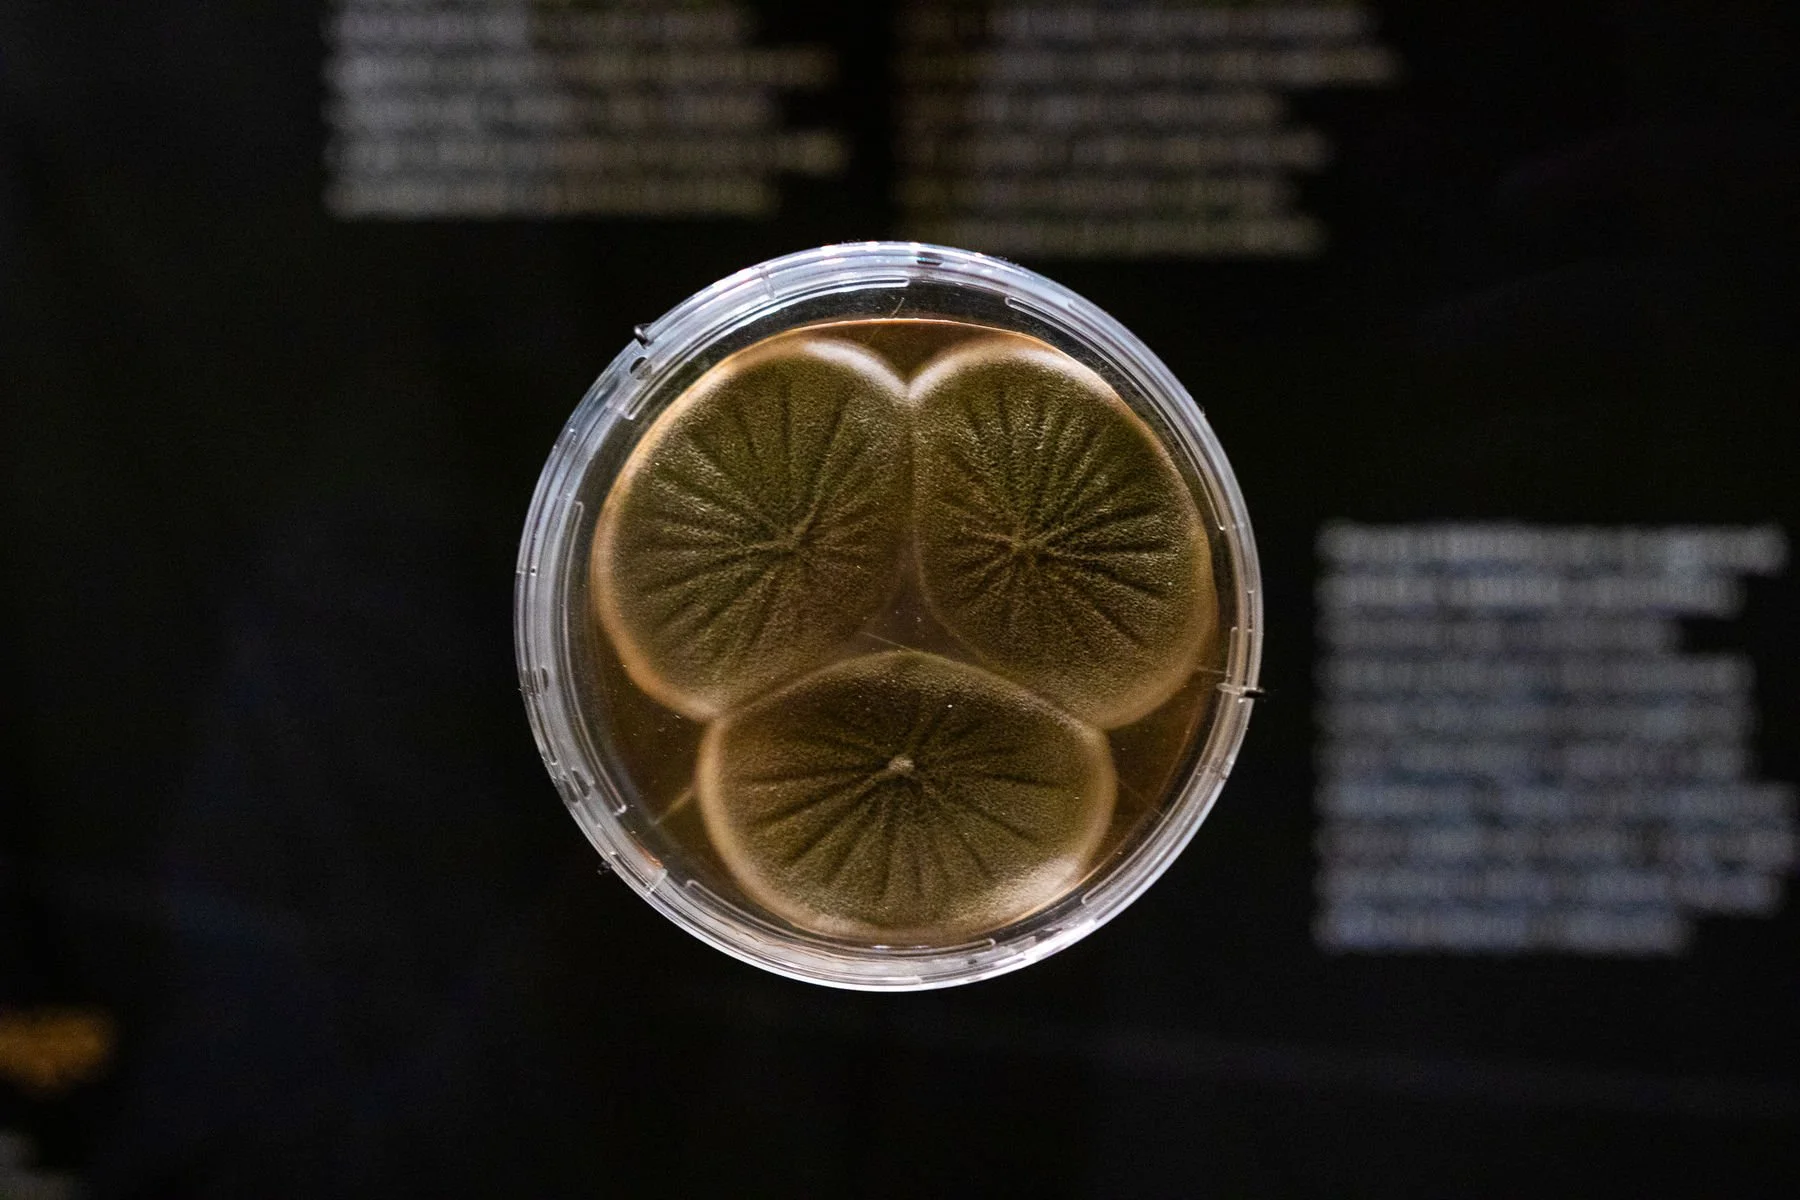
10_Svět hub, lišejníků a rostlin_©NM.jpg

Svět hub, lišejníků a rostlin
Stálá expozice v Národním muzeu
2025
investor: Národní muzeum Praha
místo: Historická budova Národního muzea
autor: Renata Slámková, Daniel Kříž, Jan Albrecht
autor scénáře: Jan Holec a kolektiv Mykologického oddělení
osvětlení: Atelier světelné techniky
lightdesign: Pavla Beranová
AV media: František Vysloužil
grafické řešení: studio Marvil
realizace: CapacityExpo, Umdasch
foto: ©Archiv NM